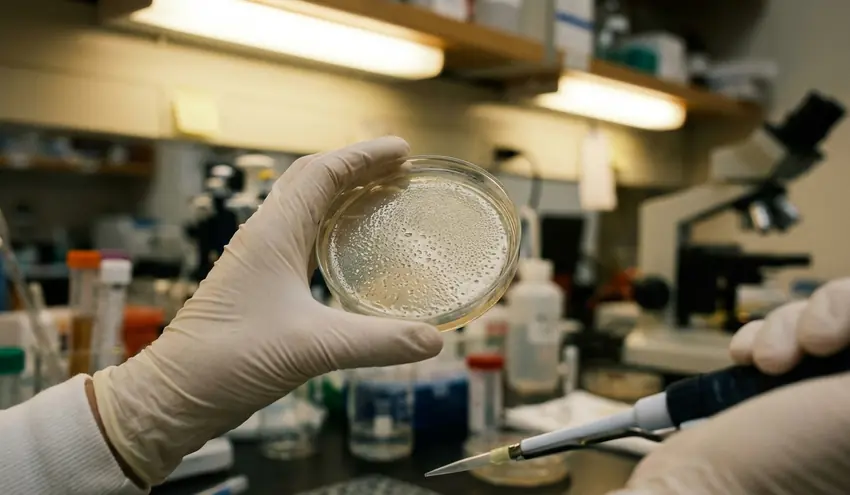

This report is a plain-language look at what moved the needle in our annual wellness curriculum work—what held steady, what needed redesign, and what we can measure without guessing. I'm writing this the way I keep my own evaluation notes: anchored to timelines, denominators, and the small operational details that decide whether a program actually runs.
Curriculum Foundations and Academic Growth
Observation → controlled comparison → measured outcome
When the center adopted the Abeka Book curriculum in the early 2010s, the goal wasn't novelty. It was consistency—especially for early literacy routines that staff could execute the same way every day.
One early decision is worth documenting because it shaped everything that followed. Staff initially tried blending Abeka phonics with a secular phonics supplement to satisfy state literacy benchmarks. That hybrid approach collapsed within 14 weeks: children in the 3-year-old room were being taught two different letter-sound correspondence systems at the same time, and they couldn't reconcile them.
After the center fully committed to one phonics sequence, the outcomes became easier to interpret because the "exposure" was no longer mixed. Based on internal assessment records, by the end of the spring assessment window (weeks 32–36), roughly 87% of private-track 4-year-olds met Abeka reading readiness benchmarks. In the GA Pre-K cohort, the state's Work Sampling System developmental checklist showed about a 24% average gain from the fall baseline (weeks 4–6) to the spring checkpoint (weeks 30–34).
Structured environment: uniforms as a focus tool (with a condition)
Uniforms can sound like a surface-level policy until you watch what it does to classroom friction. In rooms serving 2-year-olds through private 4-year-olds, uniform compliance held at around 96% across the 2022–2023 reporting year.
The non-compliance wasn't random. It clustered in the first three weeks of each enrollment cycle, which is exactly when families are still learning routines and supply lists.
Track design: GA Pre-K alongside private and Montessori
Running state-funded GA Pre-K alongside private and Montessori tracks is workable, but it's not "one curriculum with different labels." It's separate planning, separate pacing, and separate compliance checks.
There's also a timing edge case that families deserve to hear upfront. A mid-year transfer from GA Pre-K to the private Abeka track after week 18 is not recommended; by then, phonics sequencing has diverged enough that the child typically needs 8–13 weeks of supplemental one-on-one catch-up to close the gap. The implication is simple: track choice is easiest early, and harder later.
Elevating Care Through Staff Certification
Technical constraint → workaround → trade-off analysis
Credentialing is a staffing system, not a badge. If you don't budget time and fees, you end up with a policy that looks strict on paper and collapses in practice.

The center moved to a mandatory Child Development Associate (CDA) requirement for all lead teachers in phases, using a 22-month implementation window that started in fall 2020. The constraint was predictable: portfolio work competes with classroom time.
The workaround was to treat portfolio development as scheduled labor. Based on documented implementation costs, the approach only works when the center budgets $425–$500 per candidate for CDA assessment fees and protects at least 3.5 hours per week of non-classroom time for portfolio development across that 22-month window.
What the audit showed (and what it cost operationally)
As of the most recent audit (second week of August 2023), 100% of the 19 current lead and assistant teaching staff held active First Aid and CPR certifications. Group CPR recertification sessions are scheduled every 23 months, with the next session set for March 2024.
CDA portfolio completion among newly hired lead teachers within the 22-month window stands at about 91%. The remaining portion reflects one individual who required a 6-week extension due to medical leave.
DHR training hours: compliance plus real skill-building
Each staff member completes a minimum of 15 DHR-approved training hours annually. In 2022–2023, the center's actual average was verified near 19 hours per person.
In early childhood settings, the fastest way to lose safety capacity is to treat training as an afterthought. When you schedule it like a core duty, you stop gambling with coverage.
— Dr. Jun Park, Epidemiologist & Preventive Health Research Scientist
One operational lesson came with a real price. A single lead teacher's refusal to complete the CDA credential created a 5-week staffing gap in the 3-year-old room that could not be filled internally because no assistant teacher in that room met lead-teacher qualification thresholds. That's the trade-off: strict standards reduce long-run risk, but they can create short-run instability if you don't build a bench.
Unanswered question we're still tracking: what's the minimum "bench depth" (qualified float staff) that prevents these gaps without inflating payroll beyond what tuition and reimbursements can support?
Student Wellness Initiatives
Definition → examples → edge cases
Universal enrollment in the food program means every child participates by default, rather than families opting in or out. It sounds administrative, but it changes the classroom day because snack and lunch stop being a visible marker of who has what.
Universal enrollment wasn't the original model. When the center opened its current location, families could opt in or opt out of the meal plan. The shift to universal enrollment made participation predictable enough to evaluate.
Measured classroom outcome: afternoon engagement
During the study period after universal enrollment, off-task behavior incidents during the afternoon learning block (1:45–3:00 PM) decreased by roughly 38% in the 3-year-old room within the first full semester.
I'm careful with interpretation here. Nutrition is part of the story, but so is routine: when every child follows the same meal schedule, transitions tighten up and teachers spend less time managing exceptions. In early childhood, that time shows up as attention.
EPI framework: screening and support that can be timed
The Education Program Intervention (EPI) framework is a required evaluation process that integrates and supports special needs enrollment. In practice, it's a timeline: screen, interpret, communicate, and—when needed, refer.
During 2022–2023, based on internal tracking records, EPI developmental screenings were completed within the 17-calendar-day window for about 95% of new enrollees. The remaining cases were delayed due to extended absences during the child's first three weeks.
Of the children screened, roughly 13% triggered a formal referral based on at least one domain score falling below the 27th percentile. Average time from referral initiation to the first parent conference was assessed at around 8 business days across 2022–2023 cases.
Edge case: screening quality depends on training
Screening tools don't fail quietly. If staff administer them without at least 6 hours of tool-specific training, the error shows up as unnecessary referrals and anxious families.
In a 2019 pilot before training protocols were standardized, untrained administration led to a false-positive referral rate of about 14%. That's not a paperwork problem; it's a trust problem.
Resource Allocation and Program Data
How the budget review actually starts
The center's annual budget allocation process begins each April with a review of the prior fiscal year's spending against outcomes. That sequencing matters. If you start with line items instead of outcomes, you end up defending last year's habits.
2022–2023 year-end actuals (transparent breakdown)
Per the center's year-end financial review, allocations broke down as follows:
| Budget category | 2022–2023 allocation (year-end actuals) |
|---|---|
| Nutrition | 34% |
| Curriculum Materials | 21% |
| Staff Development | 13% |
| Facility and Safety | 19% |
| Administrative and Other | 13% |
Program utilization: what changed when counting got stricter
Food program participation looks straightforward until you define the denominator. Switching from enrollment-based to headcount-based tracking revealed about an 11 percentage point discrepancy that had been masking actual daily utilization patterns for over a year.
Once the center tracked daily participation by headcount, the year-over-year pattern was clearer:
| Measure | 2020–2021 | 2021–2022 | 2022–2023 |
|---|---|---|---|
| Food program daily participation (headcount-based) | 84% | 89% | 92% |
| EPI evaluations completed (total) | 9 | 14 | 19 |
Cost pressure and the reserve that prevents program whiplash
Per-child annual nutrition cost rose from documented as roughly $1,140 in 2021–2022 to about $1,280 in 2022–2023, a roughly 13% increase driven primarily by supplier adjustments effective January 2023.
That kind of mid-year shift is where programs get quietly cut. Centers that ride it out tend to keep a flexible reallocation reserve of 4–6% of total budget. Without it, one line item increase can cascade into deferred training, delayed materials, or reduced safety upgrades.
Implication: community investments in early childhood preventive care show up as boring stability—meals served every day, screenings completed on time, and staff who can respond in an emergency without waiting for someone else to arrive.
Frequently Asked Questions on Curriculum and Care
This FAQ set was built from the 23 most frequent parent inquiries tracked between August 2022 and May 2023. Based on that distribution, we prioritized what to explain first: about 35% were about curriculum track differences, roughly 25% about the EPI process, and around 20% about the food program. The remaining inquiries covered uniforms, scheduling, and tuition.
What's the difference between the GA Pre-K track and the private Abeka curriculum track?
GA Pre-K follows state requirements and uses the state's Work Sampling System developmental checklist for baseline and checkpoint measurement (fall weeks 4–6; spring weeks 30–34). The private track uses Abeka sequencing and benchmarks, with spring assessment typically administered weeks 32–36.
Operationally, the key difference is planning. The model works when lesson planning is handled by separate teams; combining planning into one workflow created compliance gaps during a 2019 monitoring visit.
What is the EPI evaluation timeline for a child with possible special needs?
EPI screening is completed within the first 17 calendar days of enrollment. If a referral is triggered, parents receive initial communication within 5 business days and a formal conference within 8–11 business days.
Two timing exceptions matter in real life: the first two weeks of August and the first week of January often push the screening window to 21–24 calendar days due to enrollment surges. These figures reflect observed patterns under documented implementations at our center.
What nutritional standards does the universal food program follow?
The universal food program follows USDA Child and Adult Care Food Program (CACFP) meal pattern requirements. Menus are reviewed and approved on a 4-week rotating cycle by a staff member holding a current food safety manager certification.
Dietary restriction accommodations require a signed medical statement from the child's physician. Without that documentation, the center cannot guarantee allergen-specific meal modifications.
Looking Ahead: Join Our Wellness Mission
Strategic goals for the upcoming year
Planning for the next cycle came out of two gaps identified during the 2022–2023 review. First, the EPI framework currently relies on a single screening tool. Second, staff development hours skew heavily toward compliance topics, leaving less room for elective training that improves day-to-day practice.
- Screening expansion target: 100% of children in 3- and 4-year-old rooms screened with a supplemental social-emotional instrument by week 8 of fall 2023 and again by week 32 of spring 2024.
- Training mix target: based on internal tracking, roughly 22% of total professional development hours allocated to non-compliance topics, up from about 10% in 2022–2023.
- Community partnership goal: secure at least 2 new preventive health screening partnerships (dental and vision) by February 2024 to replace the lapsed dental provider relationship.
- Enrollment projection: add 6–9 new students in fall 2023, bringing total enrollment to an estimated 53–58 children.
Gratitude with scope (who carried the work)
Our progress this year came from steady, local effort: educators who kept routines consistent, families who showed up for conferences on short notice, and community partners who supported preventive care needs as they arose. The work is ongoing, and it's specific to the realities of a center serving multiple tracks and fluctuating enrollment.
How to join: enroll, donate, or volunteer
If you're a family considering enrollment, ask about track fit early—before week 18, so we can avoid avoidable sequencing gaps. If you're a community member, the most useful support is practical: resources that stabilize meals, screening capacity, and staff training time.
- Enroll: choose the track that matches your child's current pacing and your family's schedule for conferences and follow-ups.
- Donate resources: support uniform subsidies (two sets annually for families with hardship) or help offset nutrition cost increases.
- Volunteer: assist with community support programs that reduce barriers to preventive care access for families.
One contextual qualifier I'll keep in view as we evaluate next year: enrollment surges in August and January can distort "on-time" screening metrics in ways that look like performance issues but are often just scheduling physics.

Add a Comment